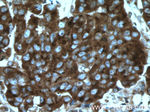
BMP15 Antibody in Immunohistochemistry (Paraffin) (IHC (P))
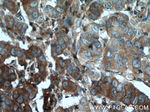
BMP15 Antibody in Immunohistochemistry (Paraffin) (IHC (P))

Search
Proteintech
BMP15 Polyclonal Antibody
{{$productOrderCtrl.translations['antibody.pdp.commerceCard.promotion.promotions']}}
{{$productOrderCtrl.translations['antibody.pdp.commerceCard.promotion.viewpromo']}}
{{$productOrderCtrl.translations['antibody.pdp.commerceCard.promotion.promocode']}}: {{promo.promoCode}} {{promo.promoTitle}} {{promo.promoDescription}}. {{$productOrderCtrl.translations['antibody.pdp.commerceCard.promotion.learnmore']}}
产品信息
18982-1-AP
种属反应
宿主/亚型
分类
类型
抗原
偶联物
形式
浓度
规格
纯化类型
保存液
内含物
保存条件
运输条件
靶标信息
BMP15, or GDF9B is a member of the bone morphogenetic protein family which is part of the transforming growth factor-beta superfamily that are involved in embryonic development and adult tissue homeostasis. BMP15 is expressed exclusively in the oocyte. It is an oocyte-specific growth/differentiation factor that may be involved in oocyte maturation and follicular development. Defects in BMP15 are the cause of ovarian dysgenesis type 2. BMP15 could be used as an oogenesis marker to track human amniotic fluid stem cells differentiation into the oocyte-like cells.
仅用于科研。不用于诊断过程。未经明确授权不得转售。
生物信息学
蛋白别名: BMP; BMP-15; Bone morphogenetic protein; Bone morphogenetic protein 15; GDF-9B; Growth/differentiation factor 9B
基因别名: AU015375; AU018861; AU021453; Bmp-15; BMP15; C86824; C87336; GDF-9B; GDF9B; ODG2; POF4
UniProt ID: (Human) O95972, (Mouse) Q9Z0L4
Entrez Gene ID: (Human) 9210, (Mouse) 12155